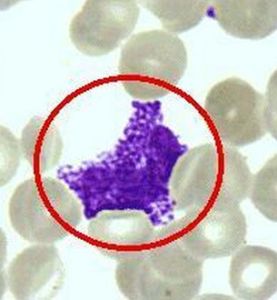
粘多糖酶

粘多糖酶臨床表現
粘多糖酶2、粘多糖貯積症II型(mucopolysaccharidosis)又稱Hunter綜合徵。XR,無女性患者,發病率為6/10萬。為艾杜糖醛酸硫酸酯酶缺乏。主征:與I型相似,但無角膜混濁,背不駝。其他:多毛,進行性耳聾;肌肉痙攣,行為莽撞。10歲後2/3患者有驚厥發作。生化診斷如I型,主要根據臨床表現相鑑別。重型者多在青春期前死亡。
輔助檢查
粘多糖沉積病是由於細胞溶酶體酸性水解酶先天性缺陷所致。根據病因目前本病可分為八大類型,我國已報告200從余例,主要表現為嚴重的骨骼畸形、腫脾腫大,智力障礙以及其它畸形。粘多糖沉積病產前診斷以測定培養羊水細胞內特異的酶活力最為可靠,但實驗要求高,一般實驗室難開展。兩種較簡單的實用的方法是甲苯胺藍定性及糖醛酸法半定量測定。
1、甲苯胺藍定性:方法同尿液粘多糖檢查。妊娠早期羊水正常者可呈陽性,妊娠中後期為陰性如陽性提示胎兒患粘多糖沉積病。
2、糖醛酸半定量測定:羊水中酸性粘多糖與四硼酸鈉硫酸溶液反應生成糖醛酸,以每毫無肌酐中糖醛酸的量反映酸性糖多糖的多少。隨著妊娠的進展,糖醛酸含量逐漸減少,妊娠16-20周的參考值為3.3--7.0mg/mgCr,如高於此值應考慮有粘多糖沉積肥病。本法除Morguio綜合徵外對其它類型的粘多糖沉積病均有診斷意義。
3、常染色體隱性遺傳病(autosomal recessive disorder):致病基因在常染色體上,基因性狀是隱性的,即只有純合子時才顯示病狀。此種遺傳病父母雙方均為致病基因攜帶者,故多見於近親婚配者的子女。子代有1/4的機率患病,子女患病機率均等。許多遺傳代謝異常的疾病,屬常染色體隱性遺傳病。按照"一個基因、一個酶"(one gene one enzyme)或"一個順反子、一個多肽"(one cistron one polypeptide)的概念,這些遺傳代謝病的酶或蛋白分子的異常,來自各自編碼基因的異常。常見的常染色體隱性遺傳病有溶酶體貯積症,如糖原貯積症、脂質貯積症、粘多糖貯積症;合成酶的缺陷如血γ球蛋白缺乏症、白化病;苯丙酮尿症、肝豆狀核變性(Wilson病)及半乳糖血症等。
化驗分析
診斷:
名稱代號
酶缺陷
酶學測定樣品生化改變
遺傳特性Hurler,Scheie綜合徵
MPSⅠ
α-L-艾杜糖酸苷酶
成纖維細胞、白細胞、組織、羊水細胞
尿和組織中DS、HS增多,成纖維細胞中DS增加
常染色體隱 性
Hunter綜合徵
MPSⅡ
艾杜糖醛酸硫酯酶
血清、成纖維細胞、白細胞、組織、羊水、羊水細胞
同上
X連隱性
Sanfilippo綜合徵A
MPSⅢA
HS-N-硫酸酯酶(硫醯胺酶)
成纖維細胞、白細胞、組織、羊水細胞
HS在尿中和組織中增多、DS在成纖維細胞中增多
常染色體隱性
Sanfilippo綜合徵B
MPSⅢB
α-N乙醯葡萄胺苷
血清、成纖維細胞、白細胞、組織、羊水細胞
Sanfilippo綜合徵C
MPSⅢC
乙醯基轉移酶
成纖維細胞
HS出現於尿中
Morquio綜合徵
MPSⅣ
N-乙醯半乳糖胺-6-硫酸酯酶
成纖維細胞
KS和CS出現於尿中
同上
Morquio綜合徵
β-半乳糖甘酶
成纖維細胞
KS出現於尿中
Maroteaux-Lamy綜合徵
MPSⅥ
N-乙醯半乳糖胺4-硫酸酯酶(芳香硫酸酯酶B)
成纖維細胞、白細胞、組織、羊水細胞
DS出現於尿中
同上
β-葡糖醛酸苷酶缺乏症無名疾病
MPSⅦ
β-葡糖醛酸苷酶
血清、成纖維細胞、白細胞、羊水細胞
DS、HS(±)出現於尿中
同上
無名疾病
MPSⅧ
N-乙醯葡糖胺6-硫酸酯酶
成纖維細胞
KS和HS(±)出現於尿中
同上
註:MPS-粘多糖沉積症DS-磷酸皮膚素
HS-硫酸乙醯肝素CD-硫酸軟骨素
KS-硫酸角質素
遺傳性粘多糖沉積症約占出生嬰兒的1/30000。